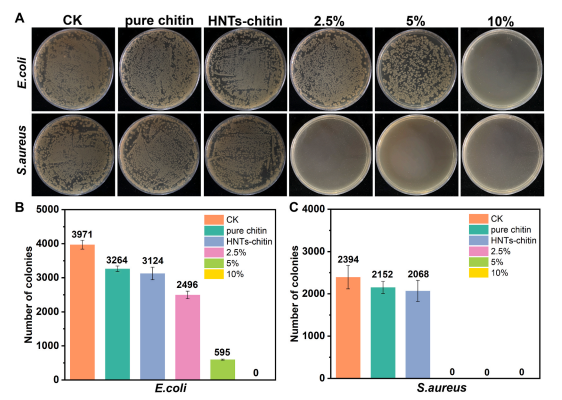
抗菌水凝胶怎么操作新型抗菌复合水凝胶——高效抗菌促进伤口愈合及止血功能_https://www.jmylbn.com_新闻资讯_第2张

伤后感染和伤口愈合一直是日常生活中不可避免的问题,因此,非常有必要设计一种具有抗菌性和良好伤口愈合性能的生物材料。在此,制备了一种以海洛石粘土和甲壳素为主要成分的伤口愈合水凝胶敷料,它结合了生物大分子和粘土的优点。纳米管(HNTs)是一种极具生物相容性的中空管状粘土材料,其内表面和外表面由不同电荷的SiOx和AlOx层组成。将直径为5-10nm的金纳米粒子填充到HNTs腔内,以增强粘土材料的光热效应。然后将Au@HNTs与甲壳素溶液混合,通过环氧氯丙烷交联制备柔性复合水凝胶。通过抗菌实验、细胞实验、小鼠肝脏和尾部止血实验,研究了该水凝胶材料的抗菌性能、生物相容性和止血性能。用金黄色葡萄球菌感染小鼠背部伤口后,将水凝胶涂于伤口上,以进一步验证水凝胶材料在体内对细菌的杀灭作用和伤口愈合作用。Au@HNTs-甲壳素复合水凝胶表现出较高的抗菌和止血活性,以及促进伤口愈合的功能,且细胞毒性低。这项研究对于开发基于两种常用生物相容性材料的高性能伤口敷料具有重要意义,它在伤口消毒和愈合方面显示出良好的应用前景。

图1. Au@HNTs-甲壳素水凝胶的制备工艺及应用示意图
为了研究 Au@HNTs-甲壳素在体内的抗菌作用和伤口愈合能力,建立了小鼠伤口感染模型并进行治疗。用剪刀在老鼠背部造成圆形伤口后,伤口被金黄色葡萄球菌感染。然后将水凝胶覆盖在伤口表面,并用红外线照射以达到杀菌效果。为了确保对正常细胞的损伤最小化,水凝胶的温度控制在45 °C 左右,水凝胶的力学性能和柔韧性几乎没有变化。在不同实验组中感染不同天数的伤口照片,以及在琼脂平板上孵育12小时后感染部位的金黄色葡萄球菌菌落照片。以无菌创面为对照组,感染后未经任何处理的创面为模型组。用 ImageJ 软件分析的伤口面积的比较。模型组创面愈合缓慢,直到第7天仍有40%的创面存在。Au@HNTs-甲壳素组创面愈合效果明显,愈合速度与对照组相当,第7天创面面积仅剩20%。
图2. Au@HNTs-甲壳素水凝胶抗菌研究
此外,Au@HNTs-甲壳素组琼脂平板上的菌落数明显少于其他组。为了证明 Au@HNTs-甲壳素对感染创面的抗菌作用,测定了感染部位组织液的 OD 值,并计算了琼脂平板上的菌落数。结果表明,Au@HNTs-甲壳素组的OD值明显低于其他实验组,菌落数也远低于其他实验组。这表明Au@HNTs-甲壳素能有效杀灭和抑制伤口感染部位的细菌生长,从而减少伤口感染,促进伤口快速愈合。由于金纳米粒子和 HNTs 在体内不可降解,所以制备的水凝胶可作为伤口愈合的临时敷料。伤口处理后,将水凝胶轻轻地从伤口中移出。胶原沉积是决定皮肤强度和外观的关键因素,因此第7天的伤口组织进行Masson染色。从蓝色染色的强度和面积可以看出,实验组间胶原沉积有显著性差异。其中,Au@HNTs-甲壳素组胶原沉积密度最高,与对照组相似。结果表明,Au@HNTs-甲壳素组的创面愈合效果最好。

图3. Au@HNTs-甲壳素水凝胶促伤口愈合研究
同时,对不同组别的小鼠进行血常规检测,不同组小鼠血液成分变化不大。并记录小鼠体重变化, Au@HNTs-甲壳素组小鼠体重呈上升趋势,与对照组一致。表明Au@HNTs-甲壳素具有较强的抗菌能力,具有良好的促进创面愈合的作用。制备的复合水凝胶的主要材料为甲壳素和海洛石,具有天然、廉价和高度生物相容性的特点。此外,明胶、透明质酸、海藻酸水凝胶等大多数商用创面愈合敷料的止血效果较差。多孔和带负电荷的 HNTs 的加入赋予了水凝胶优越的止血性能。这种水凝胶材料对伤口的临床治疗是基于装载在 HNTs 内腔和甲壳素水凝胶基质中的Au NPs的光热,而不是使用抗炎药物,从而降低患者过敏反应的风险。在实际应用中,一个治疗周期只需要几分钟就可以完成,效率高,也可以减少病人的投诉。

内源性蛋白质修饰的AuNRs——通过多种成骨信号途径增强骨修复
PH 激活有机纳米粒子——低温光热治疗眼部细菌感染
近红外-II 金纳米复合材料 /CRISPR-Cas9协同基因-光热疗法的研究
靶向肿瘤可注射水凝胶——协同光热和近距离疗法预防乳腺癌复发和伤口感染
多功能“ Janus 型”双层膜——组织粘附/药物释放实现促伤口愈合
铂纳米多酶平台调节细胞内H2O2稳态——破坏线粒体功能以实现多模式抗肿瘤
ROS清除水凝胶——糖尿病伤口修复中的免疫调节
具有可打印和抗菌特性的导电柔性贴片,用于加速伤口愈合研究
CuP纳米酶——肿瘤微环境调节剂,实现巨噬细胞极化增强免疫治疗
铂纳米修饰的 MOFs 作为多功能纳米平台——增强PDT和细胞内单线态氧的实时监测
高锰酸钾来抗肿瘤了——KMnO4原位氧化形成氧气以增强肿瘤级联治疗
二维Ti3C2/CuO2@BSA/原位纳米增敏剂——用于增强和协同声动力肿瘤治疗